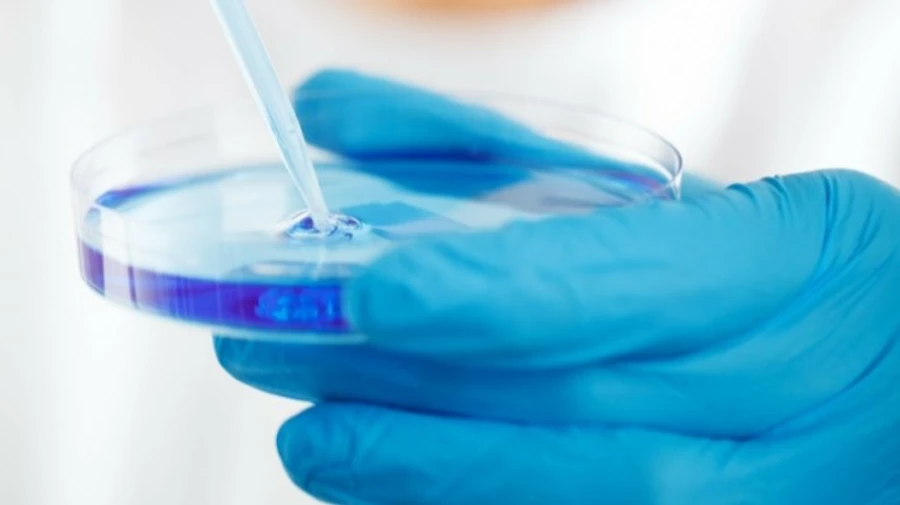
Українські ліки від коронавірусу вже тестують у Німеччині

Українські ліки від коронавірусу вже тестують у Німеччині
У німецьких лабораторіях вивчають дію низки українських медичних препаратів, які ймовірно можуть бути застосовані для лікування Covid-19.
Джерело: посол України у Німеччині Андрій Мельник в інтерв’ю Радіо Свобода
Деталі: За словами Мельника, Україні та Німеччині вдалося домовитися про те, як спільними зусиллями боротися з пандемією коронавірусу.
Пряма мова: "У нас справді є дуже непоганий досвід. Саме у німецьких лабораторіях зараз тестуються деякі вітчизняні (українські – ред.) медичні препарати, які можуть бути застосовані для лікування коронавірусу. Ми дуже активно працюємо над тим, і я сподіваюся, що будуть спільні ініціативи у розвитку вакцини, таким чином ми намагаємося звести наші наукові установи Академії наук з провідними центрами, які працюють у Німеччині.
Нагадаємо:
- Міністерство охорони здоров’я України працює над тим, аби придбати в США та доставити до України препарат Ремдесивір, який американські медики назвали дієвим при боротьбі з коронавірусом.
- Станом на 9 травня в Україні зафіксовано 14 710 випадків коронавірусу, з них 515 за минулу добу.